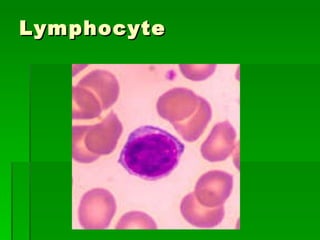
Lymphocyte
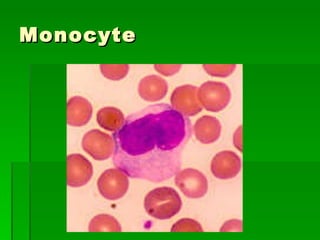
Monocyte
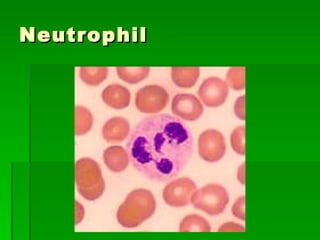
Neutrophil

This document provides an overview of the main tissues in the human body, including epithelial, connective, muscular, nervous, and vascular tissues. It describes the key characteristics and functions of each tissue type, with examples of their locations. Simple epithelial tissues include squamous, cuboidal, and columnar cells. Connective tissues include loose connective tissue, dense irregular and dense regular connective tissue, adipose tissue, and supporting tissues like cartilage and bone. The three main muscle tissues are skeletal, cardiac, and smooth muscle. Nervous tissue contains neurons, nerves, and axons. Vascular tissues comprise the blood and lymph systems.